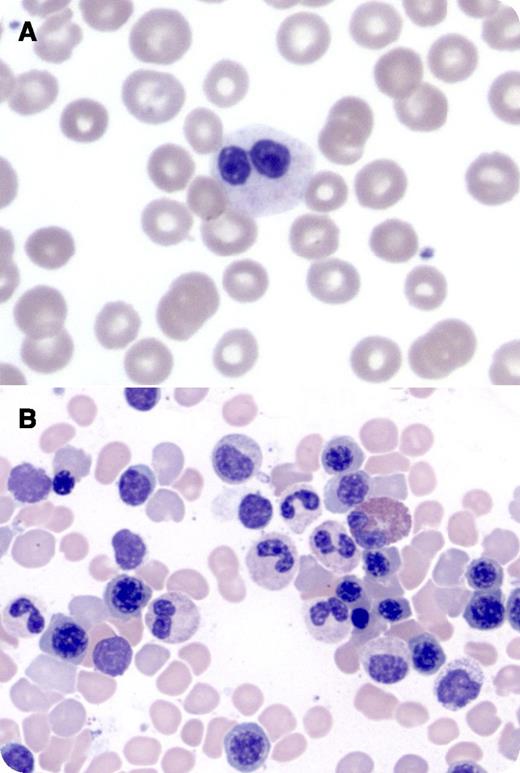
A 49-year-old man presented with hepatitis C virus cirrhosis and pancytopenia. Peripheral blood smear revealed 80% of neutrophils with bilobed nuclei and normal granulation (panel A). Bone marrow morphology demonstrated normally maturing trilineage hematopoiesis without dysplasia or ringed sideroblasts. Bilobed neutrophils were frequently seen (panel B). Flow cytometry, cytogenetics, and chromosomal genomic array testing did not demonstrate a clonal myeloid stem cell disorder. / The Pelger-Huët anomaly is characterized by neutrophils with hypolobated nuclei, including bilobed forms connected by a thin chromatin filament. Congenital Pelger-Huët anomaly is a benign condition associated with autosomal dominant inheritance of mutations in the lamin B–receptor gene and with 55% to 95% of circulating neutrophils exhibiting classic dysmorphology. Lamins create a structural link between chromatin and the internal nuclear membrane, thereby influencing nuclear shape. Acquired or pseudo Pelger-Huët can be associated with myelodysplastic syndrome, acute myeloid leukemia, chronic myeloid leukemia, and leukemoid reactions, or can be drug-induced. In these conditions, nuclear bilobation is generally asymmetric and is present in roughly 25% (clonal disorders) to 50% (drug-induced) of granulocytes. An additional distinguishing feature is chromatin clumping in multiple hematopoietic cells in the congenital form that is present only in granulocytes in the acquired anomaly. Importantly, cytopenias are not associated with congenital Pelger-Huët anomaly and likely reflect underlying hepatitis C virus cirrhosis in this case.

A 49-year-old man presented with hepatitis C virus cirrhosis and pancytopenia. Peripheral blood smear revealed 80% of neutrophils with bilobed nuclei and normal granulation (panel A). Bone marrow morphology demonstrated normally maturing trilineage hematopoiesis without dysplasia or ringed sideroblasts. Bilobed neutrophils were frequently seen (panel B). Flow cytometry, cytogenetics, and chromosomal genomic array testing did not demonstrate a clonal myeloid stem cell disorder.
The Pelger-Huët anomaly is characterized by neutrophils with hypolobated nuclei, including bilobed forms connected by a thin chromatin filament. Congenital Pelger-Huët anomaly is a benign condition associated with autosomal dominant inheritance of mutations in the lamin B–receptor gene and with 55% to 95% of circulating neutrophils exhibiting classic dysmorphology. Lamins create a structural link between chromatin and the internal nuclear membrane, thereby influencing nuclear shape. Acquired or pseudo Pelger-Huët can be associated with myelodysplastic syndrome, acute myeloid leukemia, chronic myeloid leukemia, and leukemoid reactions, or can be drug-induced. In these conditions, nuclear bilobation is generally asymmetric and is present in roughly 25% (clonal disorders) to 50% (drug-induced) of granulocytes. An additional distinguishing feature is chromatin clumping in multiple hematopoietic cells in the congenital form that is present only in granulocytes in the acquired anomaly. Importantly, cytopenias are not associated with congenital Pelger-Huët anomaly and likely reflect underlying hepatitis C virus cirrhosis in this case.
A 49-year-old man presented with hepatitis C virus cirrhosis and pancytopenia. Peripheral blood smear revealed 80% of neutrophils with bilobed nuclei and normal granulation (panel A). Bone marrow morphology demonstrated normally maturing trilineage hematopoiesis without dysplasia or ringed sideroblasts. Bilobed neutrophils were frequently seen (panel B). Flow cytometry, cytogenetics, and chromosomal genomic array testing did not demonstrate a clonal myeloid stem cell disorder.
The Pelger-Huët anomaly is characterized by neutrophils with hypolobated nuclei, including bilobed forms connected by a thin chromatin filament. Congenital Pelger-Huët anomaly is a benign condition associated with autosomal dominant inheritance of mutations in the lamin B–receptor gene and with 55% to 95% of circulating neutrophils exhibiting classic dysmorphology. Lamins create a structural link between chromatin and the internal nuclear membrane, thereby influencing nuclear shape. Acquired or pseudo Pelger-Huët can be associated with myelodysplastic syndrome, acute myeloid leukemia, chronic myeloid leukemia, and leukemoid reactions, or can be drug-induced. In these conditions, nuclear bilobation is generally asymmetric and is present in roughly 25% (clonal disorders) to 50% (drug-induced) of granulocytes. An additional distinguishing feature is chromatin clumping in multiple hematopoietic cells in the congenital form that is present only in granulocytes in the acquired anomaly. Importantly, cytopenias are not associated with congenital Pelger-Huët anomaly and likely reflect underlying hepatitis C virus cirrhosis in this case.
For additional images, visit the ASH IMAGE BANK, a reference and teaching tool that is continually updated with new atlas and case study images. For more information visit http://imagebank.hematology.org.

This feature is available to Subscribers Only
Sign In or Create an Account Close Modal